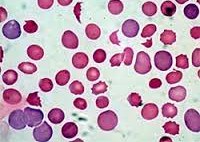

Другие названия и синонимы
Hemolytic anemia.
МКБ-10 коды
|
|
Описание
Гемолитическая анемия. Патология эритроцитов, основной характеристикой которой является ускоренное разрушение эритроцитов, с выделением повышенного количества непрямого билирубина. Для этой группы заболеваний характерно сочетание анемического синдрома, желтухи и увеличенной селезенки. В процессе диагностики, общий анализ крови, уровень билирубина, кала и мочи, УЗИ органов брюшной полости; биопсия костного мозга, иммунологические исследования. В качестве методов лечения используются препараты, переливающие кровь; при гиперспленизме показана спленэктомия.
Дополнительные факты
Гемолитическая анемия (ГА) - анемия вследствие нарушения жизненного цикла эритроцитов, а именно преобладания процессов их разрушения (эритроцитолиза) над образованием и созреванием (эритропоэз). Эта группа анемии очень обширна. Их распространенность варьируется в разных географических широтах и возрастных группах. В среднем патология встречается у 1% населения. Среди других видов анемии гемолитическая доля составляет 11%. Патология характеризуется укороченным жизненным циклом эритроцитов и их распадом (гемолизом) раньше времени (через 14-21 день вместо 100-120 дней в норме). В этом случае разрушение эритроцитов может происходить непосредственно в сосудистом русле (внутрисосудистый гемолиз) или в селезенке, печени, костном мозге (внесосудистый гемолиз).
Причины
Этиопатогенетическую основу наследственных гемолитических синдромов составляют генетические дефекты мембран эритроцитов, их ферментативных систем или структуры гемоглобина. Эти предпосылки определяют морфофункциональную неполноценность эритроцитов и их увеличение при разрушении. Гемолиз эритроцитов при приобретенной анемии происходит под влиянием внутренних факторов или факторов окружающей среды, в том числе:
• Аутоиммунные процессы. Образование антител, которые агглютинируют эритроциты, возможно при гемобластах (острый лейкоз, хронический лимфолейкоз, лимфогранулематоз), аутоиммунной патологии (СКВ, язвенный колит), инфекционных заболеваниях (инфекционный мононуклеоз, токсоплазмоз, сифилис и сифилис). Развитию иммунной гемолитической анемии могут способствовать посттрансфузионные реакции, профилактическая вакцинация, гемолитическая болезнь плода.
• Токсическое воздействие на эритроциты. В некоторых случаях острому внутрисосудистому гемолизу предшествует отравление соединениями мышьяка, тяжелыми металлами, уксусной кислотой, грибковыми ядами, алкоголем Разрушение клеток крови может быть вызвано некоторыми лекарственными средствами (противомалярийные препараты, сульфонамиды, производные нитрофурана, обезболивающие).
• Механическое повреждение эритроцитов. Гемолиз эритроцитов может наблюдаться при высоких физических нагрузках (длительные прогулки, бег, катание на лыжах), при ДВС-синдроме, малярии, злокачественной гипертонии, протезах сердца и сосудов, гипербарической оксигенации, сепсисе и обширных ожогах. В этих случаях под влиянием определенных факторов происходит травма и разрыв мембран изначально полных эритроцитов.
• Аутоиммунные процессы. Образование антител, которые агглютинируют эритроциты, возможно при гемобластах (острый лейкоз, хронический лимфолейкоз, лимфогранулематоз), аутоиммунной патологии (СКВ, язвенный колит), инфекционных заболеваниях (инфекционный мононуклеоз, токсоплазмоз, сифилис и сифилис). Развитию иммунной гемолитической анемии могут способствовать посттрансфузионные реакции, профилактическая вакцинация, гемолитическая болезнь плода.
• Токсическое воздействие на эритроциты. В некоторых случаях острому внутрисосудистому гемолизу предшествует отравление соединениями мышьяка, тяжелыми металлами, уксусной кислотой, грибковыми ядами, алкоголем Разрушение клеток крови может быть вызвано некоторыми лекарственными средствами (противомалярийные препараты, сульфонамиды, производные нитрофурана, обезболивающие).
• Механическое повреждение эритроцитов. Гемолиз эритроцитов может наблюдаться при высоких физических нагрузках (длительные прогулки, бег, катание на лыжах), при ДВС-синдроме, малярии, злокачественной гипертонии, протезах сердца и сосудов, гипербарической оксигенации, сепсисе и обширных ожогах. В этих случаях под влиянием определенных факторов происходит травма и разрыв мембран изначально полных эритроцитов.
Патогенез
Центральным звеном в патогенезе ГА является повышенное разрушение эритроцитов в органах ретикулоэндотелиальной системы (селезенка, печень, костный мозг, лимфатические узлы) или непосредственно в сосудистом русле. В случае аутоиммунного механизма анемии развиваются антиэритроцитарные антитела (термические, холодные), которые вызывают ферментативный лизис мембраны эритроцитов. Токсичные вещества, являющиеся наиболее сильными окислителями, разрушают эритроциты вследствие развития метаболических, функциональных и морфологических изменений в мембране и строме эритроцитов. Механические факторы оказывают непосредственное влияние на клеточную мембрану. Под влиянием этих механизмов ионы калия и фосфора выходят из эритроцитов, а ионы натрия входят внутрь. Клетка набухает, гемолиз происходит с критическим увеличением объема. Разрушение эритроцитов сопровождается развитием синдромов анемии и желтухи (так называемая «бледная желтуха»). Возможно интенсивное окрашивание кала и мочи, увеличение селезенки и печени.
Классификация
В гематологии гемолитическая анемия делится на две большие группы: врожденная (наследственная) и приобретенная. Наследственный ГА включает в себя следующие формы:
• мембраны эритроцитов (микросфероцитоз. Болезнь Минковского-Шоффара, овалоцитоз, акантоцитоз) - анемия вследствие структурных аномалий мембран эритроцитов.
• ферментопения (энзимопения). Анемия, вызванная дефицитом определенных ферментов (глюкозо-6-фосфатдегидрогеназы, пируваткиназы и ).
Анемия связана с качественными нарушениями структуры гемоглобина или изменением пропорции его нормальных форм (талассемия, серповидноклеточная анемия).
Приобретенные ГА делятся на:
• приобретенные сосудистые мембраны (пароксизмальная ночная гемоглобинурия. Marciafava-Mikeli b-n, клеточная анемия).
И изоиммунологический) - из-за воздействия антител.
Анемия, вызванная воздействием химических веществ, биологических ядов, бактериальных токсинов.
Анемия, вызванная механическим повреждением структуры эритроцитов (тромбоцитопеническая пурпура, запущенная гемоглобинурия).
• мембраны эритроцитов (микросфероцитоз. Болезнь Минковского-Шоффара, овалоцитоз, акантоцитоз) - анемия вследствие структурных аномалий мембран эритроцитов.
• ферментопения (энзимопения). Анемия, вызванная дефицитом определенных ферментов (глюкозо-6-фосфатдегидрогеназы, пируваткиназы и ).
Анемия связана с качественными нарушениями структуры гемоглобина или изменением пропорции его нормальных форм (талассемия, серповидноклеточная анемия).
Приобретенные ГА делятся на:
• приобретенные сосудистые мембраны (пароксизмальная ночная гемоглобинурия. Marciafava-Mikeli b-n, клеточная анемия).
И изоиммунологический) - из-за воздействия антител.
Анемия, вызванная воздействием химических веществ, биологических ядов, бактериальных токсинов.
Анемия, вызванная механическим повреждением структуры эритроцитов (тромбоцитопеническая пурпура, запущенная гемоглобинурия).
Клиническая картина
Наследственные мембранопатии, ферментопении и гемоглобинопатии.
Наиболее распространенной формой этой анемии является микросфероцитоз или болезнь Минковского-Шоффара. Наследуется по аутосомно-доминантному типу; обычно наблюдается у нескольких членов семьи. Дефектность эритроцитов обусловлена дефицитом в мембране актомиозиноподобного белка и липидов, что приводит к изменению формы и диаметра эритроцитов, их массивному и преждевременному гемолизу в селезенке. Проявление микросфероцитарной ГА возможно в любом возрасте (в младенчестве, юности, старости), однако, как правило, проявления встречаются у детей старшего возраста и подростков. Тяжесть заболевания варьирует от субклинического течения до тяжелых форм, характеризующихся часто повторяющимися гемолитическими кризами. В период кризиса температура тела, головокружение, слабость усиливаются; возникают боли в животе и рвота.Основным признаком микросфероцитарной гемолитической анемии является желтуха с различной степенью интенсивности. Из-за высокого содержания эстеркобилина стул становится интенсивно темно-коричневым. У пациентов с болезнью Минковского-Шоффара, как правило, образуются камни желчного пузыря, поэтому часто развиваются признаки обострения калькулезного холецистита, приступы желчной колики и непроходимость желтухи с закупоркой общего желчного протока. При микросфероцитозе во всех случаях увеличивается селезенка, а у половины пациентов также увеличивается печень. Помимо наследственной микросфероцитарной анемии, у детей часто встречаются другие врожденные дисплазии: башенный череп, косоглазие, деформация седлового носа, неправильный прикус, готическое небо, полидактилия или брадидактилия в капиллярах конечностей и трудно поддаются лечению.
Ферментативная анемия связана с дефицитом некоторых ферментов эритроцитов (чаще встречаются G-6-PD, глутатион-зависимые ферменты, пируваткиназа ). Гемолитическая анемия может проявиться только после интеркуррентного заболевания или приема лекарств (салицилаты, сульфонамиды, нитрофураны). Обычно болезнь ровная; типичная «бледная желтуха», умеренная гепатоспленомегалия, сердечные шумы. В тяжелых случаях развивается ярко выраженная картина гемолитического криза (слабость, рвота, одышка, сердцебиение, коллапсное состояние). Из-за внутрисосудистого гемолиза эритроцитов и выделения гемосидерина в моче последний приобретает темный (иногда черный) цвет. Независимые обзоры касаются клинического течения гемоглобинопатий - талассемии и серповидноклеточной анемии.
Ассоциированные симптомы: Анурия. Базофилия. Билирубинурия. Боль в правом подреберье. Гемоглобинурия. Гипербилирубинемия. Гиперкалиемия. Гиперурикемия. Гиперфосфатемия. Кристаллурия. Лейкопения. Ломота в мышцах. Ломота в теле. Нейтрофилез. Одышка. Покалывание в боку. Привкус крови во рту. Протеинурия. Рвота. Ретикулоцитоз. Субфебрильная температура. Цилиндрурия. Эритропения.
|
|
Возможные осложнения
Каждый тип ГА имеет свои специфические осложнения: например, желчнокаменная болезнь - при микросфероцитозе, печеночная недостаточность - при токсических формах Общие осложнения включают гемолитические приступы, которые могут быть вызваны инфекциями, стрессом и родами у женщин. При остром массивном гемолизе возможно развитие гемолитической комы, характеризующейся коллапсом, спутанным сознанием, олигурией и повышенной желтухой. Угроза жизни пациента вызвана ДВС-синдромом, инфарктом селезенки или спонтанным разрывом органа. Неотложная помощь требует острой сердечно-сосудистой и почечной недостаточности.
Диагностика
Определение формы ГА на основе анализа причин, симптомов и объективных данных является обязанностью гематолога. Во время первоначального разговора, семейной истории, частота и тяжесть гемолитических кризисов происходят. При осмотре оценивается окраска кожи, склеры и видимых слизистых оболочек, проводится пальпация живота для оценки размеров печени и селезенки. Сплен- и гепатомегалия подтверждается УЗИ печени и селезенки. Лабораторный диагностический комплекс включает в себя:
• Анализ крови. Изменения гемограммы характеризуются нормальной или гипохромной анемией, лейкопенией, тромбоцитопенией, ретикулоцитозом, ускоренным СОЭ. В биохимических пробах крови, гипербилирубинемии (увеличение непрямой фракции билирубина), определяется увеличение активности лактатдегидрогеназы. При аутоиммунной анемии положительный тест Кумбса имеет большое диагностическое значение.
• Анализ мочи и анализ кала. Анализ мочи выявляет протеинурию, уробилинурию, гемосидеринурию, гемоглобинурию. Копрограмма имеет повышенное содержание стеркобилина.
Для цитологического подтверждения выполняется стернальная пункция. Исследование пунктата костного мозга выявляет гиперплазию эритроидного зачатка.
В процессе дифференциальной диагностики исключаются гепатит, цирроз печени, портальная гипертензия, гепатолиенальный синдром, порфирия, гемобластоз. Пациента консультируют гастроэнтеролог, клинический фармаколог, специалист по инфекционным заболеваниям и другие специалисты.
• Анализ крови. Изменения гемограммы характеризуются нормальной или гипохромной анемией, лейкопенией, тромбоцитопенией, ретикулоцитозом, ускоренным СОЭ. В биохимических пробах крови, гипербилирубинемии (увеличение непрямой фракции билирубина), определяется увеличение активности лактатдегидрогеназы. При аутоиммунной анемии положительный тест Кумбса имеет большое диагностическое значение.
• Анализ мочи и анализ кала. Анализ мочи выявляет протеинурию, уробилинурию, гемосидеринурию, гемоглобинурию. Копрограмма имеет повышенное содержание стеркобилина.
Для цитологического подтверждения выполняется стернальная пункция. Исследование пунктата костного мозга выявляет гиперплазию эритроидного зачатка.
В процессе дифференциальной диагностики исключаются гепатит, цирроз печени, портальная гипертензия, гепатолиенальный синдром, порфирия, гемобластоз. Пациента консультируют гастроэнтеролог, клинический фармаколог, специалист по инфекционным заболеваниям и другие специалисты.
Лечение
Различные формы ГА имеют свои особенности и подходы к лечению. При всех вариантах приобретенной гемолитической анемии следует позаботиться о том, чтобы устранить влияние гемолитических факторов. Во время гемолитических кризов пациентам требуется инфузия растворов, плазмы крови; витаминотерапия, при необходимости - гормональная и антибиотикотерапия. В случае микросфеоцитоза единственным эффективным методом, приводящим к 100% прекращению гемолиза, является спленэктомия.
При аутоиммунной анемии показана терапия глюкокортикоидными гормонами (преднизон), которая снижает или прекращает гемолиз. В некоторых случаях желаемый эффект достигается назначением иммунодепрессантов (азатиоприн, 6-меркаптопурин, хлорамбуцил), противомалярийных препаратов (хлорохин). При резистентных к лекарствам формах аутоиммунной анемии проводится спленэктомия. Лечение гемоглобинурии включает переливание отмытых эритроцитов, плазмозаменителей, назначение антикоагулянтов и антиагрегантов. Развитие токсической гемолитической анемии обуславливает необходимость интенсивной терапии: детоксикации, форсированного диуреза, гемодиализа, как указано, - введения антидотов.
При аутоиммунной анемии показана терапия глюкокортикоидными гормонами (преднизон), которая снижает или прекращает гемолиз. В некоторых случаях желаемый эффект достигается назначением иммунодепрессантов (азатиоприн, 6-меркаптопурин, хлорамбуцил), противомалярийных препаратов (хлорохин). При резистентных к лекарствам формах аутоиммунной анемии проводится спленэктомия. Лечение гемоглобинурии включает переливание отмытых эритроцитов, плазмозаменителей, назначение антикоагулянтов и антиагрегантов. Развитие токсической гемолитической анемии обуславливает необходимость интенсивной терапии: детоксикации, форсированного диуреза, гемодиализа, как указано, - введения антидотов.
Список литературы
1. Анемии: Учебное пособие для студентов/ Сараева Н.О. 2009.
2. Гемолитические анемии у детей: учеб. - метод. пособие/ Кувшинников В.А., Шенец С.Г. 2013.
3. Анемии (клиника, диагностика, лечение). Методическое пособие/ Филатов Л.Б. 2006.
4. Клинические рекомендации по диагностике и лечению аутоиммунных гемолитический анемий/ Цветаева Н.В., Никулина О.Ф. 2014.
2. Гемолитические анемии у детей: учеб. - метод. пособие/ Кувшинников В.А., Шенец С.Г. 2013.
3. Анемии (клиника, диагностика, лечение). Методическое пособие/ Филатов Л.Б. 2006.
4. Клинические рекомендации по диагностике и лечению аутоиммунных гемолитический анемий/ Цветаева Н.В., Никулина О.Ф. 2014.
Связанные клинические рекомендации
Связанные стандарты мед. помощи
- Стандарт специализированной медицинской помощи после трансплантации аллогенного костного мозга (обследование и коррекция лечения)
- Стандарт специализированной медицинской помощи детям при талассемии трансфузионно независимой (в дневном стационаре)
- Стандарт первичной медико-санитарной помощи детям при талассемии трансфузионно зависимой
- Стандарт первичной медико-санитарной помощи детям при талассемии трансфузионно независимой
- Стандарт первичной медико-санитарной помощи при атипичном гемолитико-уремическом синдроме (динамическое наблюдение, лечение)